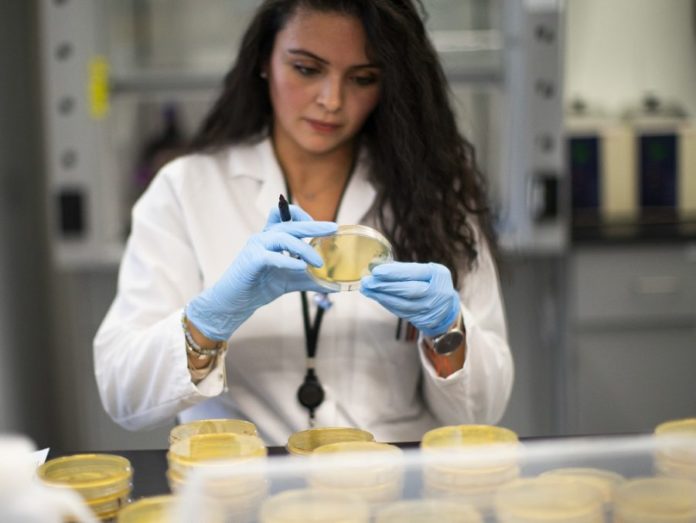

Οι περισσότεροι από εμάς αγωνιούν με το πρώτο φτέρνισμα ή την πρώτη αδιαθεσία ότι μπορεί να πάσχουν από το νέο κορωνοϊό. Η Πρότυπη Ομάδα Κλινικής Παθολογίας με ένα λεπτομερές κείμενο εξηγεί ενδελεχώς τη συμπτωματολογία κορωνοϊού, γρίπης, κρυολογήματος και αλλεργιών για να αποφευχθούν όσο το δυνατόν περισσότερο η παραπληροφόρηση και ο πανικός.
Διαβάστε αναλυτικά:
Αν έχετε καταρροή ή ερεθισμό των οφθαλμών, τότε δεν πάσχετε από COVID-19. Αντιθέτως, αν παρουσιάζετε ξηρό βήχα, αίσθημα κόπωσης και πυρετό, μάλλον πρέπει να εξεταστείτε για λοίμωξη με τον SARS-CoV-2. Ωστόσο, η παρουσία των παραπάνω συμπτωμάτων δεν είναι ειδική για τον COVID-19, καθώς τα παραπάνω συμπτώματα εμφανίζονται και σε άλλες παθήσεις, όπως η εποχική γρίπη.
Αρκετά συμπτώματα του COVID-19 εμφανίζονται και στη γρίπη ή το κοινό κρυολόγημα με αποτέλεσμα συχνά να είναι δύσκολο να γίνει διαχωρισμός ανάμεσα στις παραπάνω νόσους. Αν και προκαλούνται στο σύνολό τους από ιούς, οι παραπάνω λοιμώξεις μπορεί να προκαλέσουν νόσηση διαφορετικής βαρύτητας.
Η σημαντικότερη διαφορά ανάμεσα στις παραπάνω τρεις παθήσεις είναι η δύσπνοια, ένα σύμπτωμα που εμφανίζεται μόνο στη λοίμωξη με το νέο κορωνοϊό. Η δύσπνοια στους ασθενείς με COVID-19 εμφανίζεται συνήθως πριν την πνευμονία. Αντιθέτως, η γρίπη και το κοινό κρυολόγημα σπανίως προκαλούν δύσπνοια εκτός αν έχουν προοδεύσει σε πνευμονία. Η επιπλοκή αυτή είναι αρκετά σοβαρή, επομένως θα πρέπει να επικοινωνήσετε με τον γιατρό σας άμεσα σε περίπτωση που παρουσιάσετε το παραπάνω σύμπτωμα.
Ιδιαίτερα για το κοινό κρυολόγημα, μετά την εμφάνιση πυρετού είναι εξαιρετικά σπάνιο να εμφανιστεί δύσπνοια.
Η γρίπη, με τη σειρά της, μοιάζει αρκετά με τον COVID-19, ωστόσο η δύσπνοια που προκαλεί δεν είναι τόσο σοβαρή όσο αυτή που παρατηρείται στη λοίμωξη από SARS-CoV-2.
Στον COVID-19, η δύσπνοια εμφανίζεται συνήθως 5-10 μέρες μετά την πρώτη ημέρα του πυρετού.
Το Φτέρνισμα δεν αποτελεί σύμπτωμα του COVID-19
Το φτέρνισμα, η ρινική καταρροή, το άλγος στο πρόσωπο, η οπισθορρινική καταρροή και ο ερεθισμός των οφθαλμών αποτελούν συμπτώματα των αλλεργιών ή του κοινού κρυολογήματος.
Δεν αποτελούν κομμάτι της τυπικής κλινικής εικόνας του COVID-19.
Σύμφωνα με τον Παγκόσμιο Οργανισμό Υγείας (WHO), «τα συχνότερα συμπτώματα του COVID-19 είναι ο πυρετός, το αίσθημα κόπωσης και ο ξηρός βήχας. Ορισμένοι ασθενείς μπορεί να παρουσιάσουν επίσης άλγος, ρινική συμφόρηση, καταρροή, πονόλαιμο και διάρροια».
Μία έρευνα από την Κίνα που εξέτασε περισσότερους από 1.000 ασθενείς, διαπίστωσε ότι μόλις 1 στους 20 ασθενείς παρουσιάζει ρινική συμφόρηση.
Τα συμπτώματα του COVID-19 εμφανίζονται συνήθως 2-14 ημέρες μετά την αρχική έκθεση.
Ωστόσο, «ένας αριθμός ασθενών μπορεί να μολυνθεί από τον ιό και να μην παρουσιάσει συμπτώματα ή αίσθημα αδιαθεσίας», σύμφωνα με τον WHO.
Οι ασθενείς αυτοί μπορούν να μεταδώσουν τον ιό στο περιβάλλον τους, παρά το γεγονός ότι δεν παρουσιάζουν συμπτώματα.
Οι Αλλεργίες Συνδέονται με χρόνια συμπτώματα
Ο COVID-19, όπως και η γρίπη αλλά και το κοινό κρυολόγημα, είναι οξείες νόσοι, που σημαίνει ότι οι ασθενείς νιώθουν καλά μέχρι να αρχίσει η εμφάνιση των συμπτωμάτων της νόσου.
Οι αλλεργίες, αντιθέτως, είναι συνήθως χρόνιες και συνδέονται με εξάρσεις και υφέσεις των συμπτωμάτων τα οποία διαρκούν για εβδομάδες, μήνες ή ακόμα και χρόνια.
Οι αλλεργίες δεν μπορούν επίσης να προκαλέσουν πυρετό ή μυαλγίες. Επιπλέον, σπάνια εμφανίζεται βήχας, εκτός αν υπάρχει έντονη οπισθορρινική καταρροή.
Ένα άλλο σύμπτωμα των αλλεργιών είναι ο συριγμός, ιδιαίτερα στους ασθενείς με άσθμα.
Οι αλλεργίες επηρεάζονται επίσης από το περιβάλλον. Συγκεκριμένα, επιδεινώνονται με την έκθεση στη σκόνη, τη γύρη και τις τρίχες των ζώων. Αντιθέτως, τα συμπτώματα του κοινού κρυολογήματος διατηρούνται ανεξαρτήτως ημέρας, καιρού ή άλλων περιβαλλοντικών παραγόντων.
Το κοινό κρυολόγημα, όπως και ο COVID-19, προκαλεί συνήθως γενικευμένα συμπτώματα, όπως πυρετό, κεφαλαλγία ή μυαλγίες, ενώ οι αλλεργίες επηρεάζουν μόνο τον αναπνευστικό σωλήνα. Τέλος, τα συμπτώματα των αλλεργιών υποχωρούν μετά τη χορήγηση αντισταμινικών και άλλων αντιαλλεργικών φαρμάκων. Τα κρυολογήματα αντιμετωπίζονται συνήθως με αποσυμφορητικά, ακεταμινοφαίνη, χορήγηση υγρών και ξεκούραση.
Ο COVID-19 δεν είναι γρίπη
Καθώς ο COVID-19 προκαλείται από έναν κορωνοϊό, συγκεκριμένα τον SARS-CoV-2, έχει περισσότερα κοινά με το κοινό κρυολόγημα παρά με τη γρίπη.
Ωστόσο, παρά τα κοινά χαρακτηριστικά των κορωνοϊών με τους ιούς που ευθύνονται για το κοινό κρυολόγημα, τα τυπικά συμπτώματα του COVID-19 μοιάζουν περισσότερο με τη γρίπη (πυρετός, βήχας, πονόλαιμος, μυαλγίες, κεφαλαλγίες, αίσθημα κόπωσης) παρά με το κρυολόγημα (ρινική καταρροή, πονόλαιμος, βήχας, ρινική συμφόρηση, ήπιες μυαλγίες, ήπιες κεφαλαλγίες, φτέρνισμα, χαμηλός πυρετός, αίσθημα κακουχίας).
Τα συμπτώματα της γρίπης και του COVID-19 έχουν αρκετές ομοιότητες, με αποτέλεσμα συχνά ο διαχωρισμός των δύο νόσων με βάση αποκλειστικά τη συμπτωματολογία να είναι ιδιαίτερα δύσκολος. Κατά συνέπεια, οι ασθενείς που παρουσιάζουν συμπτώματα γρίπης, θα πρέπει να εξετάζονται και για COVID-19.
Στους ασθενείς που παρουσιάζουν ήπια συμπτώματα COVID-19 ή γρίπης, η θεραπεία είναι συνήθως συμπτωματική.
Για την αντιμετώπιση του πυρετού χορηγείται συνήθως ακεταμινοφαίνη. Για την αντιμετώπιση του βήχα χορηγούνται σταγόνες ή σιρόπι, τα οποία βοηθούν επίσης και στη διάλυση των εκκρίσεων. Σε περίπτωση που υπάρχει ρινική συμφόρηση μπορεί να χορηγηθούν και αντισταμινικά.
Πότε έχουμε Απειλητική για τη Ζωή Νόσηση
Τα ήπια περιστατικά του COVID-19 διαρκούν συνήθως περίπου 2 εβδομάδες. Ευτυχώς, ο μεγαλύτερος αριθμός των περιστατικών είναι ήπια.
Το κοινό κρυολόγημα έχει εξαιρετικά χαμηλά ποσοστά θνησιμότητας, ενώ οι αλλεργίες σπάνια είναι απειλητικές για τη ζωή.
Η γρίπη, ωστόσο, έχει μεγαλύτερο ποσοστό θνησιμότητας το οποίο είναι συνήθως κοντά στο 0.05%.
Ο COVID-19 αυτή τη στιγμή θεωρείται πιο επικίνδυνος από τη γρίπη, καθώς μεταδίδεται εύκολα, δεν υπάρχει ανοσία στον πληθυσμό και μπορεί να προκαλέσει απειλητική για τη ζωή πνευμονία.
Αν έχετε αίσθημα αδιαθεσίας ή νομίζετε ότι έχετε εκτεθεί στον SARS-CoV-2, πρέπει να παραμείνετε στο σπίτι για τουλάχιστον 2 εβδομάδες έτσι ώστε να προληφθεί η μετάδοση της νόσου.
Τα σοβαρά συμπτώματα του COVID-19 που χρειάζονται άμεση αντιμετώπιση σε νοσοκομείο περιλαμβάνουν τη δύσπνοια, το έντονο άλγος στο θώρακα που δεν υποχωρεί, τη σύγχυση και την ιώδη χρώση στα χείλη, η οποία αποτελεί ένδειξη έλλειψης οξυγόνου.
Σύμφωνα με τα δεδομένα του WHO, «σχεδόν 1 στους 6 ασθενείς που νοσεί σήμερα από COVID-19 παρουσιάζει σοβαρή νόσηση και δύσπνοια. Οι ηλικιωμένοι, καθώς και οι ασθενείς με υποκείμενες νόσους, όπως η υπέρταση, τα καρδιακά προβλήματα και ο διαβήτης, διατρέχουν αυξημένο κίνδυνο να παρουσιάσουν σοβαρή νόσηση».
Πηγή: pathologia.eu